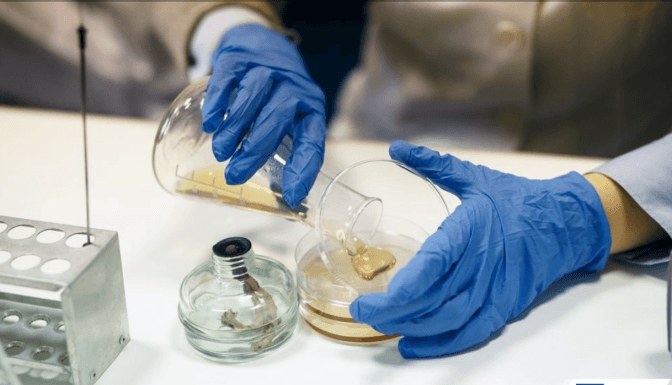
У Львові запрацювала унікальна шкільна біотехнологічна лабораторія

Новини з тегом #хімія
Що робити у разі хімічної атаки або аварії на хімпідприємстві. Інструкція
Що робити у разі хімічної атаки або аварії на хімпідприємстві. Інструкція
11 березня 2022, 13:52
ОсвітаЩо пропонує школа КМДШ та чому так важливі освітні «занурення»
Що пропонує школа КМДШ та чому так важливі освітні «занурення»
17 грудня 2021, 13:00
На правах рекламиМОН знову рекомендувало підручник з хімії, де радять лікувати рак і відбілювати зуби содою
МОН знову рекомендувало підручник з хімії, де радять лікувати рак і відбілювати зуби содою
11 грудня 2021, 14:56
CityLifeЛьвів'янин, який став останнім алхіміком Європи
Львів'янин, який став останнім алхіміком Європи
30 травня 2021, 11:00
CityLifeВчителі заклеюватимуть інформацію про протиракові властивості соди у підручниках з хімії
Вчителі заклеюватимуть інформацію про протиракові властивості соди у підручниках з хімії
26 грудня 2020, 08:05
ОсвітаУ Львові запрацювала унікальна шкільна біотехнологічна лабораторія
У Львові запрацювала унікальна шкільна біотехнологічна лабораторія
21 грудня 2020, 21:40
CityLifeУ підручнику з хімії радять лікувати рак і відбілювати зуби розчином соди. Що кажуть фахівці
У підручнику з хімії радять лікувати рак і відбілювати зуби розчином соди. Що кажуть фахівці
25 листопада 2020, 15:37
ОсвітаЛьвівські школярі отримали нагороди на міжнародній олімпіаді з хімії та фізики. Фото
Львівські школярі отримали нагороди на міжнародній олімпіаді з хімії та фізики. Фото
01 серпня 2018, 16:59
ОсвітаІнтернет-олімпіади для школярів. Як взяти участь?
Інтернет-олімпіади для школярів. Як взяти участь?
12 жовтня 2015, 17:42
ОсвітаЛьвів’ян запрошують на лекцію від нобелівського лауреата
Львів’ян запрошують на лекцію від нобелівського лауреата
28 вересня 2015, 11:41
ОсвітаКомп'ютери та побутова техніка дорожчатимуть з Нового року
Комп'ютери та побутова техніка дорожчатимуть з Нового року
08 листопада 2012, 12:26
БізнесРубрики
Розроблено:
Levprograming
За умови повного або часткового використання iнформацiї гіперпосилання на tvoemisto.tv є обов'язковим. Відповідальність за достовірність фактів, цитат, власних імен та інших відомостей несуть автори публікацій, а рекламної інформації — рекламодавці. Думка редакцiї може не збiгатися з думкою авторiв.
© 2026 "Твоє місто"